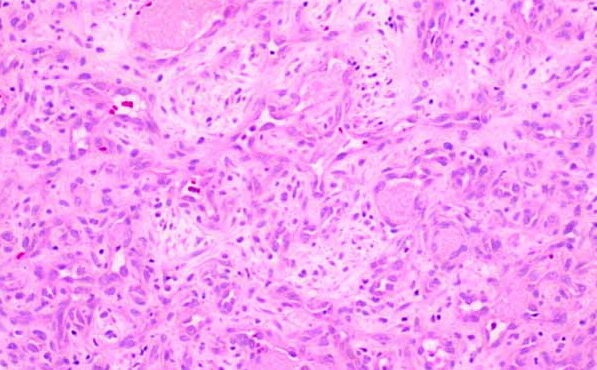
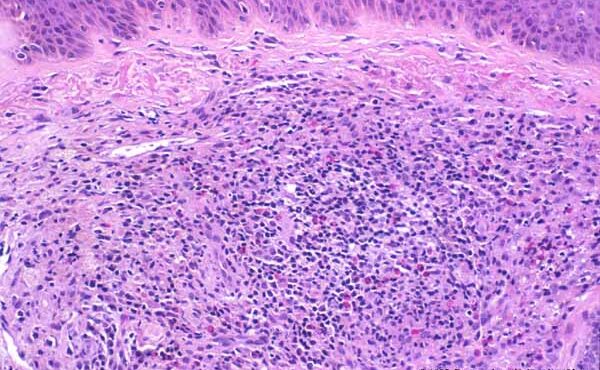
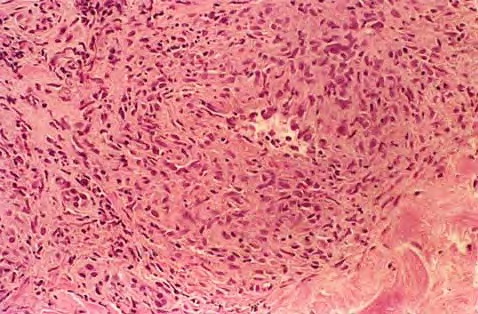

Graft versus Host Disease =داء رفض الطعم للمضيف
Graft versus Host Disease =داء رفض الطعم للمضيف Graft Versus Host Disease GVHD occurs in situations in which donor immunocompetent T cells transferred into allogenic hosts are incapable of rejecting them. The sources of the T cells include primarily peripheral blood stem cell and bone marrow transplants and, infrequently, unirradiated blood products , solid organ […]
Read More